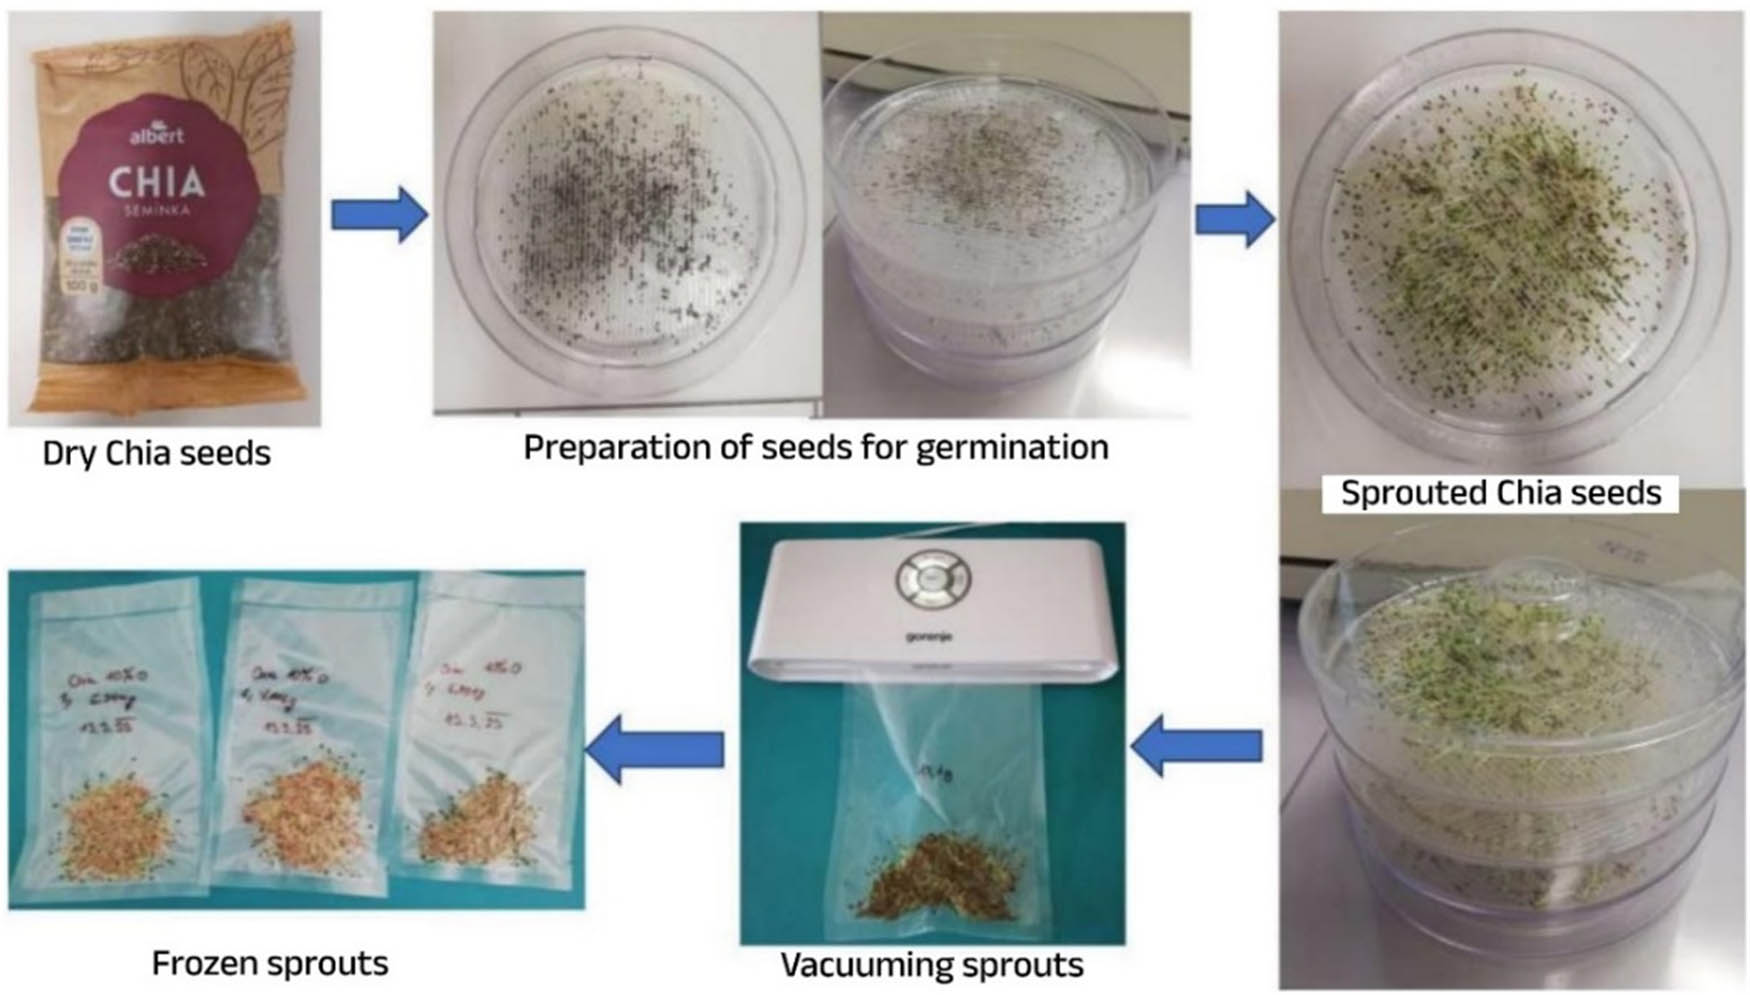
Teaser image from the article

This study was to analyze the effect of triptolide (TPL) on proliferation, apoptosis, and the relationship between TPL and the Janus kinase/signal transducer and activator of transcription signaling pathway in hepatoma cells. HepG2 cell line was selected as the experimental object and divided into control, low-dose TPL, medium-dose TPL, and high-dose TPL group. The control group did not receive any drug treatment, while the low, medium, and high-dose groups were treated with TPL at concentrations of 0.02, 0.05, and 0.10 μM, respectively. 3-(4,5-Dimethylthiazol-2-yl)-2,5-diphenyl tetrazolium bromide, flow cytometry, and western blot were used to detach the TPL effect and mechanism. The cell proliferation inhibition rate in each dose group of TPL was lower than that in the control group, and the inhibition rate of cell proliferation increased with the increase of TPL dose ( P < 0.05). The apoptosis rate of TPL in each dose group was higher than that in the control group, and the apoptosis rate increased with the increase of TPL dose ( P < 0.05). The expression of phosphorylated Janus kinase 1 (p-JAK1) and phosphorylated signal transducer and activator of transcription 3 (p-STAT3) protein in cells of each dose group of TPL was lower than that in the control group, and the expression of p-JAK1 and p-STAT3 protein decreased with the increase of TPL dose ( P < 0.05). The apoptosis rate of 10 ng/mL transforming growth factor-beta + high-dose group was reduced than that in the high-dose group, and the expression of p-JAK1 and p-STAT3 protein was higher than that in the high-dose group ( P < 0.05). The activity of B-cell lymphoma/leukemia-2-associated X protein (Bax) protein and cysteine aspartic acid protease (Caspase)-3/9 in TPL cells at each dose was raised than that in the control group, and the expression of B-cell lymphoma/leukemia-2 (Bcl-2) protein was decreased than that in the control group. With the increase of TPL dose, the activity of Bax protein and Caspase-3/9 increased, and the Bcl-2 protein decreased ( P < 0.05). As an anti-liver cancer agent, TPL inhibits the proliferation of hepatocellular carcinoma cells and promotes apoptosis. The mechanism may involve inhibiting Janus kinase 1/signal transducer and activator of transcription 3 pathway and activation of apoptosis-related pathways.
Contents
- Biomedical Sciences
-
January 28, 2025
-
February 25, 2025
-
March 11, 2025
-
Open AccessPrimary pleomorphic liposarcoma involving bilateral ovaries: Case report and literature reviewMarch 21, 2025
-
March 25, 2025
-
Open AccessAeromonas veronii-induced septic arthritis of the hip in a child with acute lymphoblastic leukemiaMarch 28, 2025
-
April 1, 2025
-
April 1, 2025
-
Open AccessAssociation between PAX9 or MSX1 gene polymorphism and tooth agenesis risk: A meta-analysisApril 10, 2025
-
April 10, 2025
-
Open AccessCase of nasopharyngeal tuberculosis complicated with cervical lymph node and pulmonary tuberculosisApril 14, 2025
-
Open Accessp-Cymene inhibits pro-fibrotic and inflammatory mediators to prevent hepatic dysfunctionApril 15, 2025
-
April 25, 2025
-
April 25, 2025
-
April 25, 2025
-
April 29, 2025
-
Open AccessSmall cell lung cancer with small intestinal metastasis: Case report and literature reviewApril 29, 2025
-
May 12, 2025
-
June 10, 2025
-
June 12, 2025
-
Open AccessResearch progress on the regulation of autophagy in cardiovascular diseases by chemokinesJune 17, 2025
-
July 7, 2025
-
July 8, 2025
-
July 8, 2025
-
July 11, 2025
-
Open AccessInnovations in MALDI-TOF Mass Spectrometry: Bridging modern diagnostics and historical insightsJuly 18, 2025
-
July 18, 2025
-
Open AccessHypereosinophilic syndrome with elevated IgG4 and T-cell clonality: A report of two casesJuly 24, 2025
-
August 1, 2025
-
Open AccessAnalysis of the detection rate and related factors of thyroid nodules in the healthy populationAugust 5, 2025
-
August 8, 2025
-
August 8, 2025
-
August 8, 2025
-
August 8, 2025
-
August 11, 2025
-
August 12, 2025
-
August 18, 2025
-
Open AccessThe NuA4/TIP60 histone-modifying complex and Hr78 modulate the Lobe2 mutant eye phenotypeAugust 20, 2025
-
Open AccessA case of IgA nephropathy treated with a combination of telitacicept and half-dose glucocorticoidsAugust 28, 2025
-
Open AccessWound healing and signaling pathwaysSeptember 1, 2025
-
September 1, 2025
-
September 8, 2025
-
Open AccessDapagliflozin attenuates atrial fibrosis via the HMGB1/RAGE pathway in atrial fibrillation ratsSeptember 8, 2025
-
September 17, 2025
-
September 23, 2025
-
October 3, 2025
-
Open AccessTreatment of pure red cell aplasia in a chronic kidney disease patient with roxadustat: A case reportOctober 4, 2025
-
Open AccessThe TNFR-RIPK1/RIPK3 signalling pathway mediates the effect of lanthanum on necroptosis of nerve cellsOctober 14, 2025
-
Open AccessConstruction of pectinase gene engineering microbe and its application in tobacco sheetsOctober 18, 2025
-
October 29, 2025
-
Open AccessHeat stroke associated with novel leukaemia inhibitory factor receptor gene variant in a Chinese infantOctober 30, 2025
-
Open AccessMerkel cell carcinoma: Clinicopathological analysis of three patients and literature reviewNovember 7, 2025
- Ecology and Environmental Science
-
Open AccessIndices of human impacts on landscapes: How do they reflect the proportions of natural habitats?April 28, 2025
-
Open AccessGlobal assessment of the fate of nitrogen deposition in forest ecosystems: Insights from 15N tracer studiesSeptember 18, 2025
-
September 20, 2025
-
Open AccessEleonora’s falcon trophic interactions with insects within its breeding range: A systematic reviewNovember 5, 2025
- Agriculture
-
July 15, 2025
-
Open AccessMolecular mechanism of follicular development in laying hens based on the regulation of water metabolismOctober 30, 2025
- Animal Science
-
Open AccessEffect of sex ratio on the life history traits of an important invasive species, Spodoptera frugiperdaFebruary 25, 2025
- Plant Sciences
-
March 7, 2025
-
Open AccessThe DREB7 transcription factor enhances salt tolerance in soybean plants under salt stressAugust 20, 2025
-
Open AccessUsing plant electrical signals of water hyacinth (Eichhornia crassipes) for water pollution monitoringOctober 18, 2025
- Food Science
-
February 19, 2025
-
June 17, 2025
-
Open AccessImpact of saline sprouting on antioxidant properties and bioactive compounds in chia seedsJuly 24, 2025
-
Open AccessThe dilemma of food genetics and improvementAugust 2, 2025
- Bioengineering and Biotechnology
-
May 20, 2025
- Corrigendum
-
Open AccessCorrigendum to “Effects of Ire1 gene on virulence and pathogenicity of Candida albicans”September 30, 2025